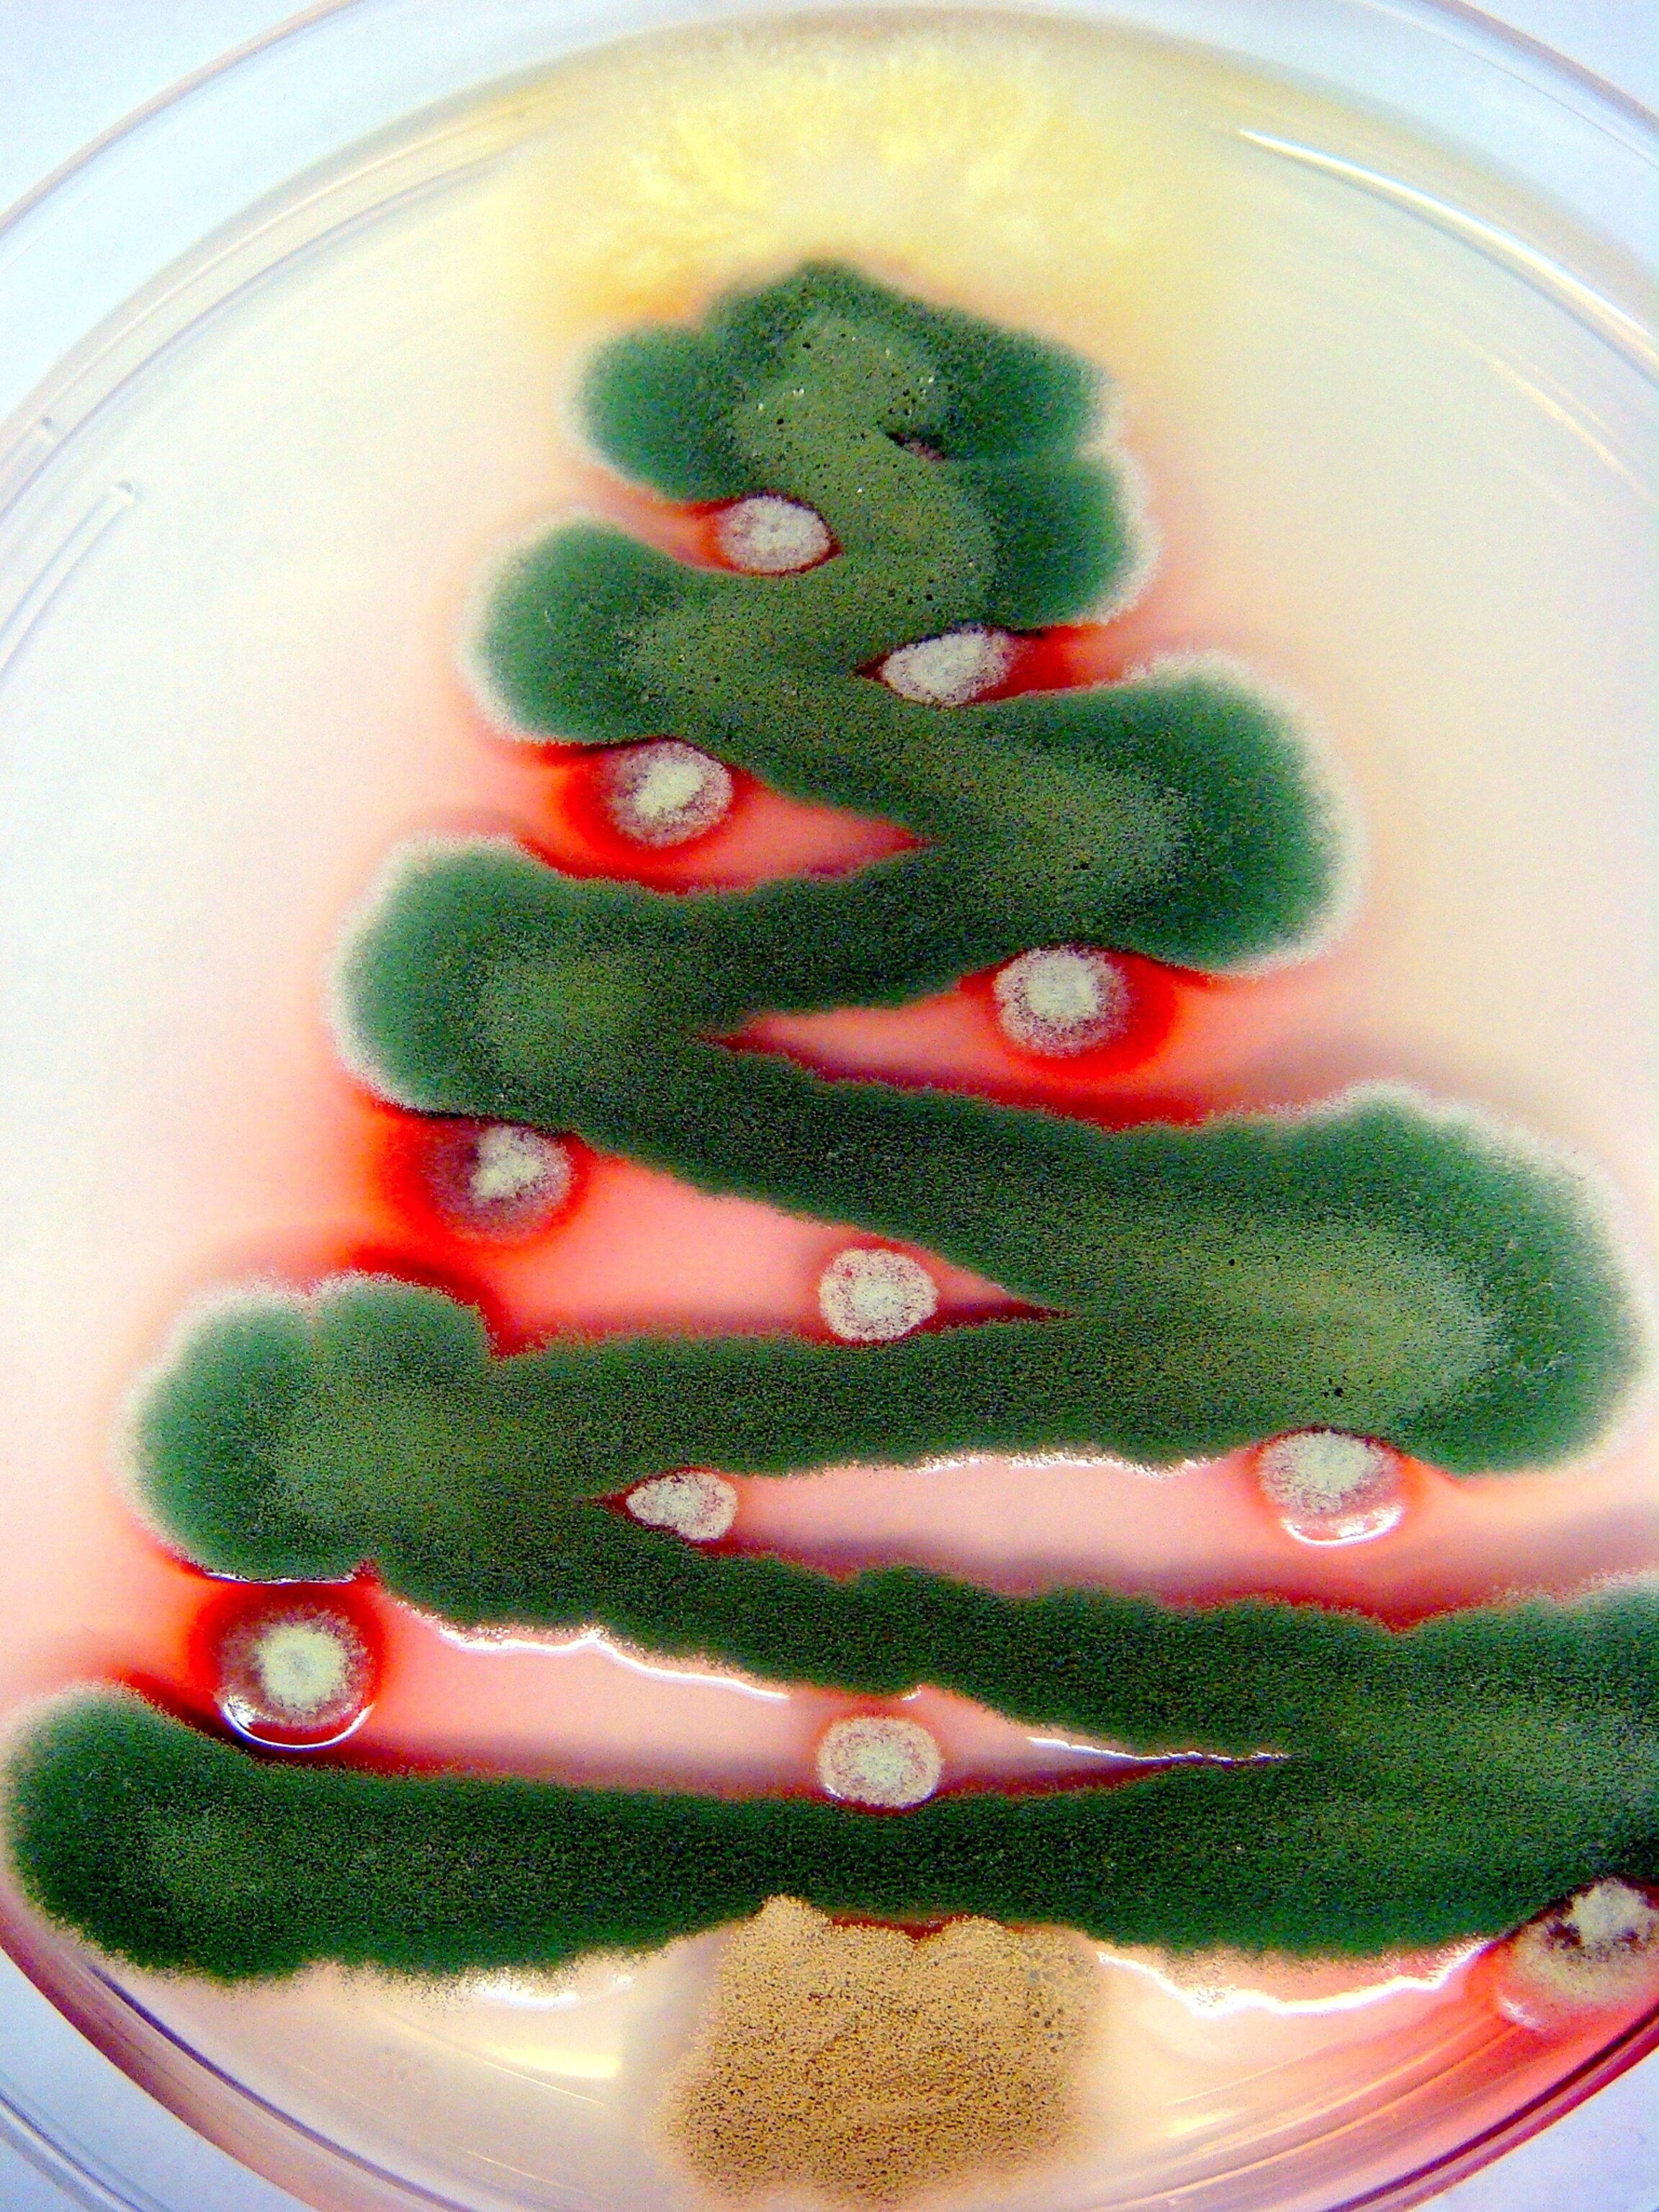
a Christmas tree made from fungi

Fuzzy FrostyThis smiling Frosty is no ordinary snowman—he's made entirely of mold. The living artwork is the creation of Stephanie Mounaud, an infectious disease researcher at the J. Craig Venter Institute (JCVI) in Rockville, Maryland.For the last several Christmases, Mounaud has used the different strains of mold that she works with to create holiday-themed fungal art.The snowman pictured here was made by combining four different fungi, including common strains such as Aspergillus niger and rarer ones such as Penicillium marneffei.Getting the colors just right for her artwork was tricky and required growing the right fungi on the right medium. For example, "the color that you see in the snowman is made from the spores," hardy reproductive forms of fungi used for dispersal, Mounaud explained.To coax the fungi to create spores, Mounaud used a nutrient-poor growth medium. "When you give them a starved condition, the fungi really want to produce their spores because they feel they're in an environment where they need to survive," she said. (See a video on the hunt for the abominable snowman.)
Photograph courtesy Stephanie Mounaud, J. Craig Venter Institute
Pictures: Fungi Get Into the Holiday Spirit
One researcher coaxes mold into seasonal artwork.
Published December 23, 2012